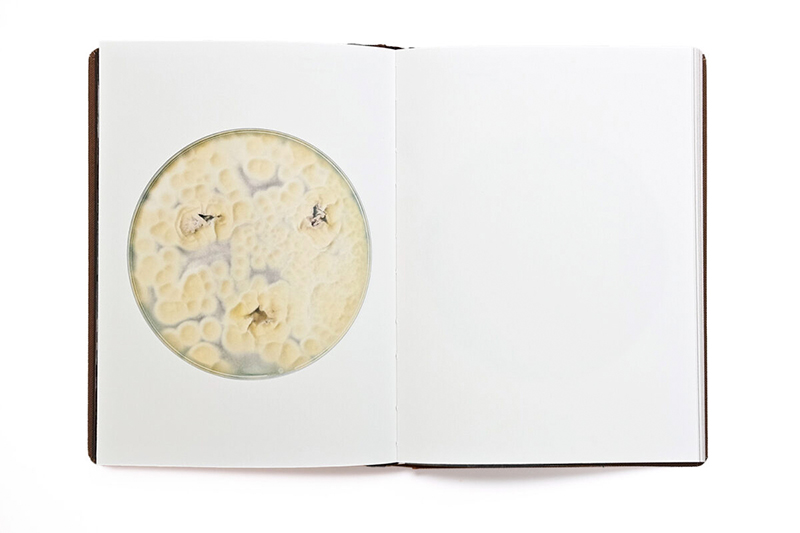

Nicolai Howalt – Fungi (Signed)
€50.00
Out of stock
Fungi contemplates a realm largely invisible to the naked eye, yet as essential to life on Earth as sunlight and oxygen. Working at the intersection of artistic experimentation and scientific inquiry, Nicolai Howalt integrates different species of fungi into his creative and photographic processes, allowing these enigmatic organisms to directly influence the visual and material outcomes of the work.
Inside light-sealed boxes, Howalt has cultivated spores from selected fungal species directly onto unexposed analog photographic paper. As the fungi feed on the paper’s gelatin surface, they consume parts of the photographic emulsion, leaving behind traces that only appear once the paper is developed in the darkroom. The result is a series of photogram images created by the fungi themselves—organic compositions that reveal the delicate mycelium networks through the gradual deterioration of the paper.
Other spores have been carefully grown in Petri dishes and scanned in high resolution, producing images that unveil a vivid, microscopic world of fungal forms and colors that normally remain unseen. In another process, Howalt grows fungi into paper-thin layers and leaves them to dry over several months. Once dried, these fragile, translucent sheets are used as unique fungal negatives in the darkroom.
Each image unfolds as a quiet dialogue between human intention and non-human agency: traces of life briefly lived on light-sensitive paper, marks formed through nourishment and erosion, fragile imprints of growth and decay, presence and disappearance.
* Signed by the artist *
Show featured artists